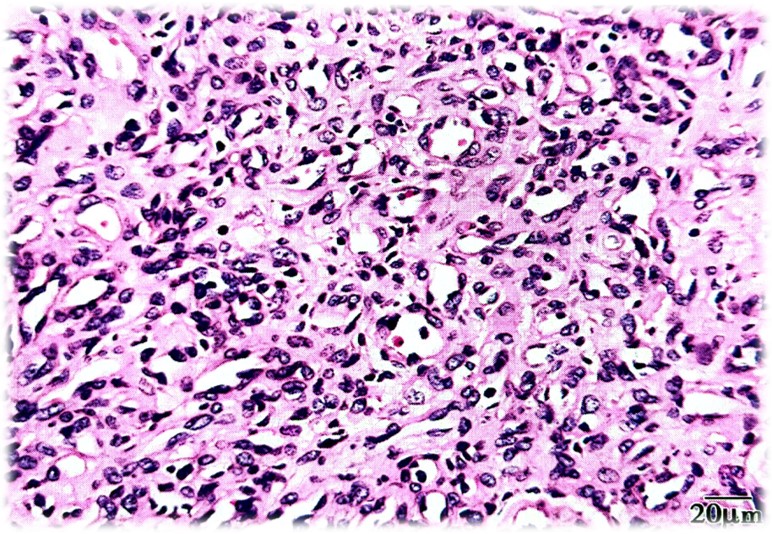

-
1 章节要点
-
2 章节测验
良性肿瘤和瘤样病变
★一、牙龈瘤
是指牙龈局限性慢性炎性增生。创伤和慢性刺激,特别是龈下菌斑和结石是其主要病因,临床表现为牙龈局限性肿大,常见牙间组织,牙龈瘤术后有复发倾向,主要原因是局部菌斑和结石除去不全和(或)手术切除不完全。根据病理学变化,牙龈瘤可分为纤维性龈瘤、血管性龈瘤和巨细胞性龈瘤。
(一)纤维性龈瘤
肉眼观:有蒂或无蒂包块,质地坚实,颜色与附近牙龈相同,不易出血。

图16.1-1 纤维性龈瘤(肉眼)
光镜下:纤维性龈瘤由富于细胞肉芽组织和成熟的胶原纤维束组成,胶原纤维束之间有浆细胞为主炎性细胞浸润(图16.1-2)。

图16.1-2 纤维性龈瘤(光镜)
(二)血管性龈瘤
又称化脓性肉芽肿或妊娠性牙龈瘤,其病因与妊娠有关。
肉眼观:质软、紫红色包块(图16.1-3),常伴有溃疡和出血。

图16.1-3 血管性龈瘤(肉眼)
光镜下:血管内皮细胞增生呈实性片状或条索,或弥散的薄壁小血管,间质水肿,炎细胞浸润(图16.1-4)。

图16.1-4 血管性龈瘤(光镜)
(三)巨细胞性龈瘤
一般认为是一种损伤后的反应性增生。
肉眼观:包块,有蒂或无蒂,呈暗红色,可发生溃疡。
光镜下:富于血管和细胞的间质内含有多核破骨细胞样细胞,呈灶性聚集(图16.1-5)。

图16.1-5 巨细胞性龈瘤
二、纤维瘤
是常见的口腔纤维组织增生性病变,非真性肿瘤。
肉眼观:结节性肿块。
光镜下:结缔组织致密、纤维化,被覆上皮变薄、上皮钉突萎缩(图16.1-6)。

图16.1-6 纤维瘤
三、炎症性乳头状增生
是一种炎症性反应性组织增生。
光镜下:黏膜上皮乳头状增生,表面被覆增生的复层鳞状上皮,间质有淋巴细胞和浆细胞为主的慢性炎症细胞浸润。
★四、血管瘤和血管畸形
好发于唇、舌、颊等处,具有多发性、无包膜,切除不彻底可复发等特点。
(一)血管瘤
血管瘤包括婴儿血管瘤和分叶状毛细血管瘤。
1.婴儿血管瘤
婴儿最常见的良性肿瘤,其特征为在围生期或先天发病,在出生后第一年迅速增生,之后自行消退,浅表的肿块呈红色,深部肿块呈蓝色,最常累及头颈部(60%),多为单发,约1/5为多发性。
光镜下:1)增生期:丰硕的增生性内皮细胞,构成无包膜的团块状小叶,并形成含红细胞的小腔隙(图16.1-7)。2)退化期:血管数量明显增加,细胞变扁,管腔增大,扩张的毛细血管排列紧密,结缔组织间质少。3)末期:病变为纤维和脂肪性背景。
图16.1-7 婴儿血管瘤(增生期)
2.分叶状毛细血管瘤
获得性血管瘤,是生长迅速的外生性病变。多数认为是一种增生性而不是肿瘤性病变。
临床表现:好发儿童和青年,男性远超女性,以牙龈、口唇、面部多见,肿块呈息肉状,可有蒂,表面有溃疡。
光镜下:病变呈息肉状,突起于黏膜,表面糜烂,由纤维性间隔分隔病变,呈分叶状形态(图16.1-8)。

图16.1-8 分叶状毛细血管瘤
(二)血管畸形
它是指血管的结构异常,不伴有内皮细胞增生,出生即有,且终身存在。分为静脉畸形和动静脉畸形。
1.静脉畸形
由生长缓慢、血流动力学不活跃的畸形血管组成。肉眼观察,呈蓝色,触之柔软,可被压缩,境界欠清,低头实验阳性。
光镜下:病变由大量薄壁血管构成,血管腔大小不规则;管腔相互吻合且充满血液;管壁内衬一层扁平的内皮细胞,管壁外一般无平滑肌纤维(图16.1-9)。

图16.1-9 静脉畸形
2.动静脉畸形
是高流量的病变,因为动脉和静脉直接相通,触摸肿块可感觉到搏动或听诊时有血管杂音,主要见于头颈部。
光镜下:病变主要由厚壁血管组成,被覆单层内皮细胞,还有少量薄壁扩张血管和不等量的黏液(图16.1-10)。

图16.1-10 动静脉畸形
五、淋巴管瘤。
多为先天性,儿童多见,口腔内好发舌前部的舌背黏膜。
光镜下:以壁薄,大小不等扩张的淋巴管为特点,内衬扁平内皮细胞,腔内空或含有蛋白样液体(图16.1-11)。

图16.1-11 淋巴管瘤
六、先天性颗粒细胞龈瘤。
瘤细胞体积大,胞浆丰富,含嗜酸性颗粒,呈片块状,紧密排列;核呈圆形或卵圆形,间质少,血管丰富(图16.1-12)。

图16.1-12 先天性颗粒细胞龈瘤
七、颗粒细胞瘤
肿瘤由丰满的含嗜酸性颗粒细胞构成。细胞呈多边形,胞核小、深染,细胞膜不明显,胞质含大量均质颗粒(图16.1-13)。

图16.1-13 颗粒细胞瘤
八、神经鞘膜瘤
又称施万细胞瘤,是施万细胞来源的良性神经性肿瘤。
光镜下:可见两种不同的组织学结构,A区,梭形的施万细胞呈旋涡状或栅栏状排列,B区瘤细胞稀少,排列成疏松的网状结构(图16.1-14)。

图16.1-14 神经鞘膜瘤
九、嗜酸性淋巴肉芽肿
为肉芽肿结构,其主要特征一是嗜酸性粒细胞和淋巴细胞灶性或弥漫性浸润;二是病变血管增生(图16.1-15)。

图16.1-15 嗜酸性淋巴肉芽肿

